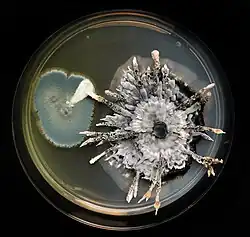

Penicillium polonicum
| Penicillium polonicum | |
|---|---|
| |
| Xylaria against Penicillium | |
| Scientific classification | |
| Kingdom: | Fungi |
| Division: | Ascomycota |
| Class: | Eurotiomycetes |
| Order: | Eurotiales |
| Family: | Aspergillaceae |
| Genus: | Penicillium |
| Species: | P. polonicum
|
| Binomial name | |
| Penicillium polonicum Zalessky, K.M. 1927[1]
| |
| Type strain | |
| Biourge 276, CBS 222.28, IBT 12821, IMI 291194, MUCL 29204, NRRL 995, QM 7596, Thom 5010.33[2] | |
| Synonyms | |
|
Penicillium aurantiogriseum var. polonicum[1] | |
Penicillium polonicum is a species of fungus in the genus Penicillium which produces penicillic acid, verucosidin, patulin, anacine, 3-methoxyviridicatin and glycopeptides.[1][3][4][5][6] Penicillium polonicum can spoil cereals, peanuts, onions, dried meats, citrus fruits[4][7]
Further reading
- Núñez, F; Díaz, M. C.; Rodríguez, M; Aranda, E; Martín, A; Asensio, M. A. (2000). "Effects of substrate, water activity, and temperature on growth and verrucosidin production by Penicillium polonicum isolated from dry-cured ham". Journal of Food Protection. 63 (2): 231–6. doi:10.4315/0362-028x-63.2.231. PMID 10678429.
- Aranda, E.; Rodrı́Guez, M.; Benito, M.J.; Asensio, M.A.; Córdoba, J.J. (2002). "Molecular cloning of verrucosidin-producing Penicillium polonicum genes by differential screening to obtain a DNA probe". International Journal of Food Microbiology. 76 (1–2): 55–61. doi:10.1016/S0168-1605(02)00008-9. PMID 12038578.
- Saccomori, Fernanda; Wigmann, Évelin Francine; Bernardi, Angélica Olivier; Alcano-González, María de Jesús; Copetti, Marina Venturini (2015). "Influence of storage temperature on growth of Penicillium polonicum and Penicillium glabrum and potential for deterioration of frozen chicken nuggets". International Journal of Food Microbiology. 200: 1–4. doi:10.1016/j.ijfoodmicro.2015.01.014. PMID 25647332.
- Ding, Guang-Zhi; Liu, Jing; Wang, Jia-Ming; Fang, Lei; Yu, Shi-Shan (2013). "Secondary metabolites from the endophytic fungi Penicillium polonicumand Aspergillus fumigatus". Journal of Asian Natural Products Research. 15 (5): 446–452. doi:10.1080/10286020.2013.780349. PMID 23600807. S2CID 302886.
- Mantle, Peter G.; McHugh, Katharine M.; Fincham, John E. (2010). "Contrasting Nephropathic Responses to Oral Administration of Extract of Cultured Penicillium polonicum in Rat and Primate". Toxins. 2 (8): 2083–2097. doi:10.3390/toxins2082083. PMC 3153284. PMID 22069673.
- Ulrich Kück; Minou Nowrousian; Jürgen Reiß; Birgit Hoff; Ines Engh (2009). Schimmelpilze: Lebensweise, Nutzen, Schaden, Bekämpfung. Springer Science & Business Media. ISBN 978-3540887164.
- Manfred Hinker; Martina Seibert (2013). Pilze in Innenräumen und am Arbeitsplatz. Springer-Verlag. ISBN 978-3709112359.
References
- ^ a b c MycoBank
- ^ Straininfo of Penicillium polonicum
- ^ IniProt
- ^ a b Duduk, N.; Vasić, M.; Vico, I. (2014). "First Report of Penicillium polonicum Causing Blue Mold on Stored Onion (Allium cepa) in Serbia". Plant Disease. 98 (10): 1440. doi:10.1094/PDIS-05-14-0550-PDN. PMID 30703962.
- ^ Sarah De Saeger (2011). Determining Mycotoxins and Mycotoxigenic Fungi in Food and Feed. Elsevier. ISBN 978-0857090973.
- ^ Martha J. Boss; Dennis W. Day (2002). Biological Risk Engineering Handbook: Infection Control and Decontamination. CRC Press. ISBN 142003216X.
- ^ Núñez, F; Díaz, M. C.; Rodríguez, M; Aranda, E; Martín, A; Asensio, M. A. (2000). "Effects of substrate, water activity, and temperature on growth and verrucosidin production by Penicillium polonicum isolated from dry-cured ham". Journal of Food Protection. 63 (2): 231–6. doi:10.4315/0362-028x-63.2.231. PMID 10678429.